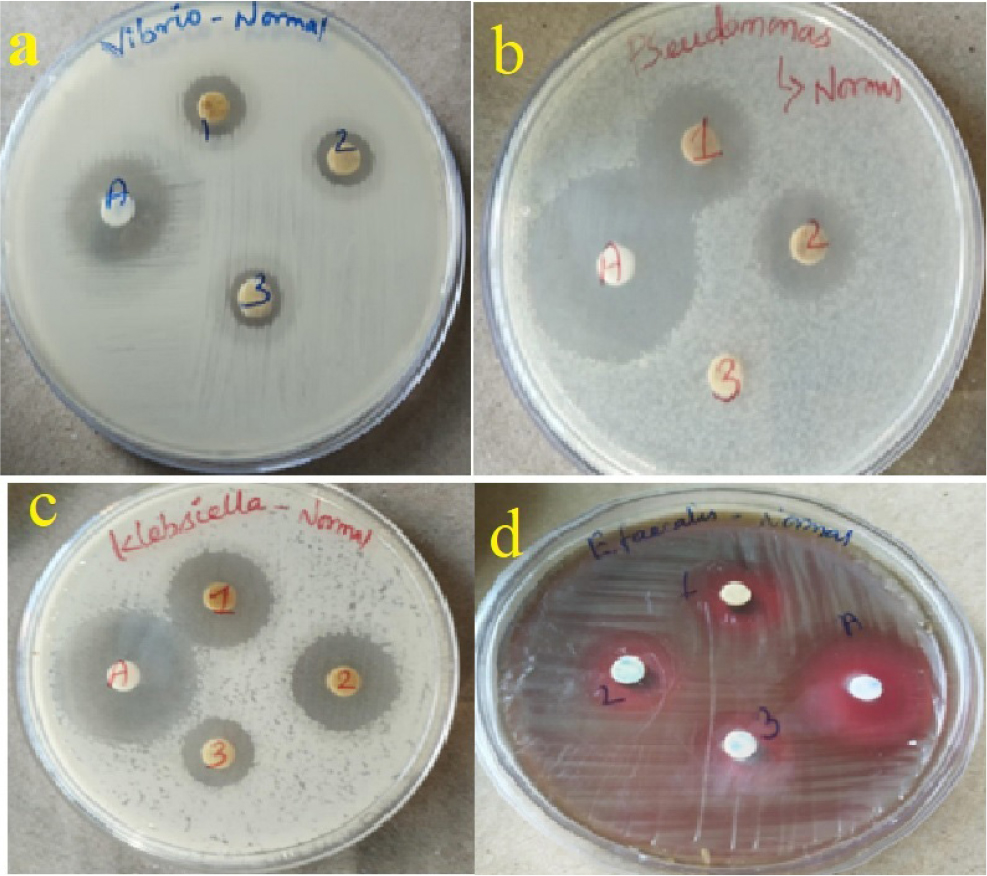
https://cdn.apub.kr/journalsite/sites/mrsk/2026-036-01/N0340360101/images/mrsk_2026_361_001_F7.jpg
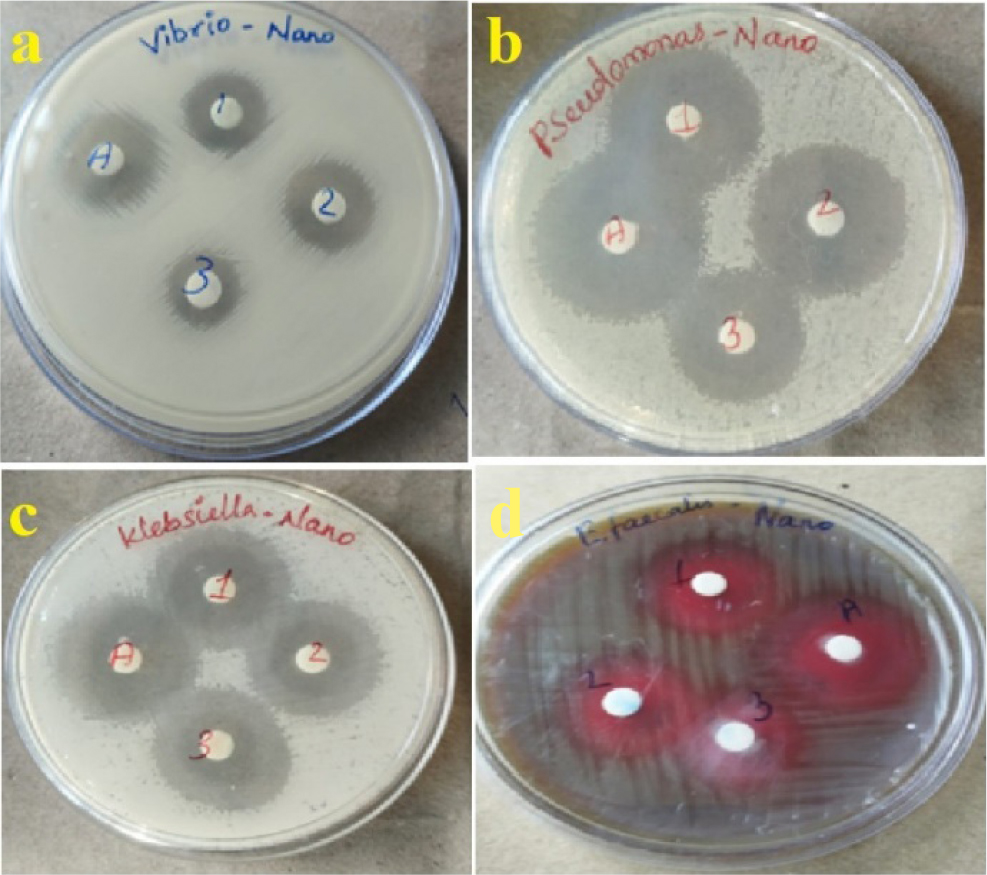
https://cdn.apub.kr/journalsite/sites/mrsk/2026-036-01/N0340360101/images/mrsk_2026_361_001_F8.jpg

1. Introduction
2. Experimental Procedure
2.1. Piper longum fruits extract preparation
2.2. Phytochemical assessment
2.3. Preparation of silver nanoparticles
3. Instrumental Techniques
3.1. UV-visible spectroscopy
3.2. FT-IR spectrum analysis studies
3.3. Powder X-ray diffraction analysis
3.4. SEM with EDX analysis
4. Biological Activities
4.1. Antimicrobial activity
4.2. Cell line culture study
5. Results and Discussion
5.1. UV-Vis spectrum
5.2. FT-IR study
5.3. X-ray diffraction study
5.4. SEM with EDX analysis
5.5. Antibacterial test
5.6. PL-AgNPs - inhibition of HeLa cells
6. Conclusion
1. Introduction
The field of nanotechnology in contemporary synthetic chemistry is mainly concerned with the development and manufacture of nanoparticles and their hybrids, which can have a variety of sizes, shapes, and chemical compositions which are valuable in many industries.
The use of green chemistry in the manufacture of nanoparticles is currently common.1,2) Although clean, precisely defined nanoparticles can be produced using chemical and physical techniques, doing so is costly and can have negative environmental effects if thrown carelessly.3) As a result, green synthesis uses plant extract as a substitute technique of creating nanoparticles.4) The plant extract’s primary component, polyphenols, has both capping and reducing activities.
Silver Nanoparticles (Ag-NPs) possess potential applications in a range of sectors, such as electronics, food processing, cosmetics, solar cell, wastewater management, forensic science, pharmaceuticals, medicine, imaging and drug delivery.5,6) Ag-NPs are often produced using conventional techniques; however, these techniques frequently produce poisonous byproducts, demand the use of risky materials as reducing agents, also need a significant amount of additional energy.7) In order to avoid using dangerous chemicals in the production of nanoparticles, there is a great desire to create effective energy-based green chemical methods.8,9)
In order to produce nanoparticles of metal and its oxides in a variety of sizes on a large scale, which is necessary to get over these obstacles, plants are the suitable environmentally friendly resource.10) Because they are abundant in organic chemicals such as alkaloids, amino acids, polysaccharides and phenolic compounds such as phenylpropanoids, terpenoids and flavonoids.11,12) that may efficiently convert metal to metal nanoparticles with a single process and for the production of (metal) Ag-NPs, plant extract is an excellent substitute.2,11) By varying the reducing and capping agents and its concentration, the nanoparticles’ sizes and shapes can be changed.13)
Members of the Piperaceae family, Piper longum and Piper nigrum are commonly known as “Indian long pepper” and “black pepper,” respectively, and have been utilised by Asian cultures to control pests. Numerous tropical and subtropical nations, including India, Sri Lanka, Indonesia, Philippines, Malaysia, Nepal, Java, Vietnam and Thailand, cultivate these plants.
These herbs have been utilized as food additives for years due to their ability to aid in digestion as well as their decongestant, antimicrobial, and analgesic characteristics.14) In addition to its several uses, Piper nigrum and its products can be used to cure hypertension, fever, inflammation, diarrhea, spasmodic disorder, microbial infections, thyroid disorder and prevent the liver damage and spread of cancer cells and used for detoxification.15) Piper longum fruit has a strong scent, is spicy, and is stimulating. The unripe, dried berries are also used as a black pepper adulterant and as a garnish in pickles and curries. It is taken orally to treat stomach aches, headaches, rhinitis, vomiting, acid regurgitation, and indigestion. In addition, it serves to treat asthma, bronchitis, rheumatoid arthritis, sciatica and epilepsy.16)
Because of the enormous potential influence Ag-NPs might have on medicine, this plant has been used in addition to its previously mentioned medical benefits to create Ag-NPs. Ag-NPs are most frequently used in lotions in medicine to prevent infections caused by microbes brought on by wounds, burns and cuts.16) Furthermore, the nature of Ag-NPs was identified to extremely hazardous to a variety of human disease caused by multidrug-resistant organisms. When Ag-NPs were evaluated for their ability to destroy cancer cells, it was discovered that lung cancer cell lines showed more efficiency.17) Combining the use of plant extract with silver to treat tumors may result in synergistic cytotoxicity against cancer cells.18) The research into the development of safe and efficient therapeutic medications to treat a variety of malignancies using natural substances as curative agents is thus the main focus of study. The process of producing Ag-NPs using Piper cubeba and examining their antimicrobial, antioxidant, and anticancer activities were carried out.19) In the current study, stable Ag-NPs were produced in an environmentally friendly manner and characterized using fruit extracts from Piper longum as reducing agents. Only a few studies on the HeLa cell line have been carried out and reported earlier.20) This study aims to ascertain the impact of Ag-NPs produced from Piper longum fruit extract on the HeLa cell line, which has not been reported previously. The obtained results are compared for their selective anticancer behavior with normal cell lines under in vitro conditions.
2. Experimental Procedure
2.1. Piper longum fruits extract preparation
Fresh Piper longum fruits (Fig. 1) were bought in Chennai, India, and Sigma-Aldrich chemicals supplied the silver nitrate (AgNO3) in the AR grade. Fruits that had just been purchased were properly cleaned, rinsed with water (distilled), and then let to air dry in ambient temperature with the shade. The dried fruit was then crushed and pounded using a pestle and mortar into a fine powder. Using an orbital shaker with a 200-rpm speed setting, 250 mL of methanol and 50 g of fine powder were combined, and the mixture was then heated for 4 h at 37 °C. The extracted materials were refrigerated and processed through Whatman filter paper, grade 1 for subsequent analysis.21)
2.2. Phytochemical assessment
The phytochemical composition of Piper longum fruit methanol extract was investigated and reveals the presence of many chemicals including coumarone, anthocyanin, carbohydrates, flavonoids, alkaloids, proteins, terpenes, betacynanins, lignans, quinones, saponins, tannins, starch, steroids, C-glycosides, acids, phenol, and terpenoids using standard biochemical procedures.
2.3. Preparation of silver nanoparticles
The Song method was used to perform a green synthesis of Ag-NPs. In 250 mL flasks, 90.0 mL of silver nitrate’s 1.0 mM aqueous solution and 10.0 mL of fruit extract were mixed. After centrifugation at the rate of 10,000 rpm speed for about ten minutes at the temperature of 4 °C, redispersion in distilled water is performed. Visually observable color transformation of the colourless reaction solution into a coloured one (Fig. 2) which confirmed that Ag-NPs are being formed throughout the reduction phase. For further characterization, the remaining pellet was frozen and preserved.
3. Instrumental Techniques
3.1. UV-visible spectroscopy
UV-visible spectrometer allows it to be simple to witness how Ag-NPs are created by reducing a suitable metal-ion solution with fruit extract. The metal content and absorption spectra of fruit extract quantities were evaluated using a PerkinElmer Lambda-45 spectrophotometer in the 300-800 nm range.
3.2. FT-IR spectrum analysis studies
The Ag-NPs were examined using an IR Affinity-1 spectrometer made by Shimadzu, which has a spectral region from 4,000 to 400 cm-1 and with a resolution up to 0.5-16 cm-1. Similar to powder diffraction measurements, powder sample for fourier transform infrared spectroscopy (FT-IR) measurements were generated. After synthesizing Ag-NPs, the FT-IR spectra were examined to look into possible functional groups for their formation.
3.3. Powder X-ray diffraction analysis
Using a BRUKER D8 model instrument, the silver nano particle’s size and type were identified at voltages of 2,200 operating at 40 kV and 40 mA with Cu Kα radiation (λ = 1.5418 Å). In continuous scan mode, the scanning was done in the range of 20 to 90°. Before producing a thick coat of aliquots on the plate for X-ray diffraction (XRD) measurement, a small number of aliquots were first dropped onto the glass plate and allowed to dry.
3.4. SEM with EDX analysis
Quanta FEG-250 by FEI-Thermo Fisher scanning electron microscope (SEM) was used to study the platinum-coated Ag-NPs after they had been equally distributed and ion coated for 120 s. Energy-dispersive X-ray spectroscopy (EDX) was used to evaluate and identify the components in powdered Ag-NPs.
4. Biological Activities
4.1. Antimicrobial activity
According to the disc diffusion method described by Bauer et al.22) was used to assess the antibacterial effectiveness of metal Ag-NPs made from methanol extract of Piper longum fruits. Cleared-out blank discs were submerged in the material for around two hours on a Petri dish. The discs were now prepared for usage. In already-colonized Mueller-Hinton agar (MHA) plates, discs were inserted. An hour of diffusion was followed by a 24 h incubation period at 37 °C for the plates. The zone of inhibition (ZOI) was calculated by a conventional measurement. Millimetre scaling was adopted to measure the ZOI. Ampicillin (10 µg/mL) was the antibiotic used as the positive control.23)
4.2. Cell line culture study
HeLa cell line was provided by the NCIM, a Pune-based organisation. The cells were maintained at 37 °C in a humid atmosphere with 5 % CO2 in Minimal-Essential-Medium (MEM) supplemented with 10 % FBS, 100 U/mL of Penicillin, and 100 µg/mL of Streptomycin.
4.2.1. Cytotoxicity assay (MTT assay)
The cells were grown at the temperature of 37 °C with 5 % CO2 after being sown onto 24-well plates with 1 × 105 cells per well. After coming to a confluence, after adding the samples, the cells were cultured for a further twenty-four hours. Following the culture, the samples were taken out of the well and cleaned with MEM, which is either phosphate buffered saline (pH 7.4) or serum-free. After that 0.1 mL/well at the concentration of 0.5 % (5 mg/mL) of 3-(4, 5-dimethyl-2-thiazolyl)-2, 5-diphenyl-tetrazolium bromide (MTT) were added before the incubation period of four hours began. One millilitre of DMSO was applied to each well right after incubation. Using DMSO as the blank, the UV-spectrophotometer was used to detect the absorbance at nearby 570 nm. Measurements were taken during the tests to determine the concentration (IC50) at which 50 % inhibition took place. Based on a specified formula, the percentage of viable cells was calculated as given below
5. Results and Discussion
A qualitative analysis of the Piper longum methanol fruit extract’s initial phytochemical screening was conducted, and the results are summarised in Table 1 Phytochemical analysis of methanol extract of Piper longum fruit. The findings indicated the of various classes of secondary metabolites, which are important in herbal medicine. The availability of tannins, quinones, flavonoids, alkaloids, phenol, glycosides, carbohydrates, proteins, steroids, and terpenoids in Piper longum was discovered, as well as the absence of acid, anthocynins/betacynanins, coumarins, cardiac glycosides, starch, saponins. According to other research, a range of plant metabolites, such as terpenoids, flavonoids, phenols, polyphenols, amines, alkaloids, saponins, aldehydes, ketones, arabinose, and galactose, are involved in the synthesis of Ag-NPs. The results indicated that PL Ag-NPs were chosen for further study on its antibacterial, antioxidant, and anticancer qualities because it contained more phytochemicals. These early phytochemical assays are crucial for identifying chemical components in plant matter.
Table 1.
Phytochemical analysis of methanol extract of Piper longum fruit.
5.1. UV-Vis spectrum
This work details a thorough investigation into the production of Ag-NPs utilizing Piper longum fruit methanol extract. Methanol extracts of Piper longum were transformed into Ag-NPs when silver nitrate solution was added. After a 24 h reaction, the solution’s colour shifted from yellow to brilliant yellow to brown, demonstrating the emergence of Ag-NPs. Using an ultraviolet-visible spectrophotmeter, we assessed reduced Ag-NPs formation and stability in colloidal solution. The maximum absorbance was noted in the UV-visible spectrum at the range of 430 to 470 nm after silver nitrate was incubated with plant extract over an extended duration which confirms the formation of nanoparticles (Fig. 3).24)
5.2. FT-IR study
The biomolecules in charge of capping and effective stability of metal nanoparticles made by Piper longum methanol extract have been found using FT-IR measurements. Fig. 4 displays the Ag-NPs FT-IR spectra. The peak at 3345.43 cm-1 represents O-H. The assignment correlates to primary amines with N-H bends at 1640.36 cm-1. When silver nitrate is added, the peaks at 1237.61 cm-1, which indicate the aromatic amine group C-N stretching, are entirely suppressed, indicating that the Ag-NPs have been reduced and stabilized. The bio-reduction of silver nitrate (AgNO3) solution to Ag-NPs is demonstrated to be significantly influenced by the transmittance percentages of the ketone, fluoro, and amine groups.
5.3. X-ray diffraction study
The crystalline structure of the green synthesised PL Ag-NPs was determined using powder XRD. The produced Ag-NPs’ XRD pattern is shown in Fig. 5. With two theta values of 32.50, 37.8900, 44.2300, 64.2600 and 77.2400 which indicating the (101), (111), (200), (220) and (311) planes, respectively, and the Bragg’s reflections are seen indicate that the prepared Ag-NPs are identified as face centred cubic (FCC) structure.25,26)
5.4. SEM with EDX analysis
In addition, elemental silver had been identified using EDX. The EDX image of synthesized Ag-NPs from Piper longum extract is given in Fig. 6. The data obviously display a strong surface plasmon resonance (SPR) signal strength roughly at 2.98 keV, consistent with the presence of metal-Ag-NPs.25) The normal absorption of oxygen and carbon is shown by the other strong signal, which ranges from 0.0 to 0.5 Kilo eV. This demonstrates that on the surface of Ag-NPs, the Piper longum fruit extract functions as a capping inhibitor.26)
5.5. Antibacterial test
The results of the anti-bacterial test by Piper longum methanol extract and synthesized silver NPs are presented in Table 2 and Table 3. When used against gram bacterial infections, the generated Ag-NPs demonstrated remarkable antibacterial activity. Minimum Inhibitory Concentrations (MIC) of 1 mg/mL, 0.75 mg/mL, and 0.5 mg/mL are used to analyse the data and their resulting images are shown in Fig. 7 [Fig. 7(a-d) antibacterial activity of Piper longum methanol extract for different pathogens] with different inhibition rate were presented which indicated that antibacterial activity exhibitions of Piper longum. Ag-NPs show greater ZOI for Pseudomonas SP. (26 mm) and Klebsiella Sp. (25 mm) for against all pathogenic bacteria tested, whereas Enterococcus faecalis (23 mm) and Vibrio Sp. (17 mm) had good zones of inhibition. The appearance of an inhibitory zone surrounding the well demonstrated the anti-bacterial properties of Ag-NPs.
Table 2.
Antibacterial activity of Piper longum methanol extract for different Bacteria.
Table 3.
Antibacterial activity of PL Ag-NPs for different Bacteria.
On comparing the results with piper longum synthesized Ag-NPs which demonstrated excellent inhibition rate with different pathogens as shown in [Fig. 8(a-d) antibacterial activity of PL Ag-NPs for different pathogens] when compared with piper longum extract. Similar outcomes for Ag-NPs anti-bacterial effectiveness against both bacteria (gram +ve and gram -ve) and many resistant strains, were reported in earlier articles. Furthermore, it was discovered that Streptomyces sp.-derived Ag-NPs displayed reactive anti-bacterial action was shown against pathogens such Proteus vulgaris, Staphylococcus aureus (S. aureus), Escherichia coli (E.coli), Bacillus cereus and Salmonella typhi.19) From the obtained results, fruit extract and synthesized Ag-NPs resulted with different inhibitory regions for different concentration levels which reinforces the greatest surface area activity. The different MIC levels were tested against different pathogens that explained the results on the basis of cellular wall of each strain (both gram positive and negative). The structural effects of extract-synthesized Ag-NPs were investigated for their rate of inhibition, and the results show that cellular wall content is a key factor.
5.6. PL-AgNPs - inhibition of HeLa cells
The MTT assay was used to evaluate the antiproliferative effects of biosynthesized Ag-NPs in HeLa cells. In this study, the minimal inhibitory concentration (IC50) values for tumor-inhibitory effect are determined. As depicted in Fig. 9, various concentrations were used to treat with the Hela cell lines and given in Table 4. The cell viability results for extract synthesized Ag-NPs are shown in Fig. 10 for differing concentrations between 1,000 µg/mL to 7.8 µg/mL. A significant result for biosynthesized Ag-NPs were observed and found to exhibit increased cell mortality in HeLa cells, their dead cells was noticed after 24 h. As the concentration of PL-Ag-NPs grew, the rate of cell death increased steadily indicating that necrosis or apoptosis may be the most likely mechanisms for cell death.
Table 4.
PL-Ag-NPs anti-cancer effects on the HeLa cell line.
Table 5.
Anticancer impact of PL-Ag-NPs on VERO Cell line.
Ag-NPs were shown to have cell viability of 14.8 % and 83.9 % at 1,000 µg/mL and 7.8 µg/mL. concentrations, accordingly. HeLa cell viability was reduced concentration-dependently (IC50 value of 62.5 at 54 % of inhibition) when exposed to Ag-NPs was observed by MTT assay. Evidence demonstrating the cytotoxic impact of bio-synthesized Ag-NPs utilizing Annona squamosa leaf extract against the MCF-7 breast cancer cell line also significantly supports the findings of this investigation,27) Piper longum (PL) leaf extract opposes the Hep-2 cancer cell line Jacob et al.28) and Against HeLa cell lines by extract of Morinda citrifolia.21) The PL-Ag NPs induced cell death was also tested for their selective antiproliferative characteristics. To observe the toxicity behavior with normal cell line (VERO cell line), dose dependent manner with IC50 concentration. This study showed that the biosynthesized nanoparticles are less toxic toward normal cells. The cytotoxic behavior on normal cell line tested capability was shown in Fig. 11 and given in Table 5. Microscopic examination was used to capture the change in cell line morphology, as seen in Fig. 10 and Fig. 11. Cell membranes are affected by nanoparticles having structural characteristics. Results of the extract-created Ag-NPs were observed to have specific antiproliferative properties in HeLa cell line cancer cells.
6. Conclusion
In this study, morphological silver nanostructure were synthesised and characterised using optical and microscopic approaches utilising Piper longum fruit extract as a reductant. The SPR in UV-visible spectra has verified the creation of Ag-NPs (from silver positive ion to neutral silver) (max at 441-564 nm). The planes (101), (111), (200), (220) and (311) intersected at 32.50, 38.120, 44.310, 64.450 and 77.410 respectively, supporting the crystalline structure of FCC silver in the powder XRD data. SEM study reveals that particles that were spherical form and micro-sized dendrites with particle sizes between 70 and 100 nm, diameters between 0.7 and 2.5 nm, and lengths between 3.3 and 30 nm, The EDX spectrum supports the existence of a sizeable silver by the formation of peak at 3.25 KeV. As stated by the antibacterial assay findings, the test bacterium Pseudomonas sp. may be effectively inhibited from growing when exposed to Ag-NPs produced by Piper longum fruit extracts. The synthesised Ag-NPs and the extracts efficiently suppressed the cancerous HeLa cells, as shown by the toxic abilities of nanoparticles prepared from aqueous and acetone extracts, which revealed IC50 values at substantially lower concentrations compared with the other values. Their selective behaviour also tested using normal VERO cell line which explored less number of dead cells than the HeLa cell line.